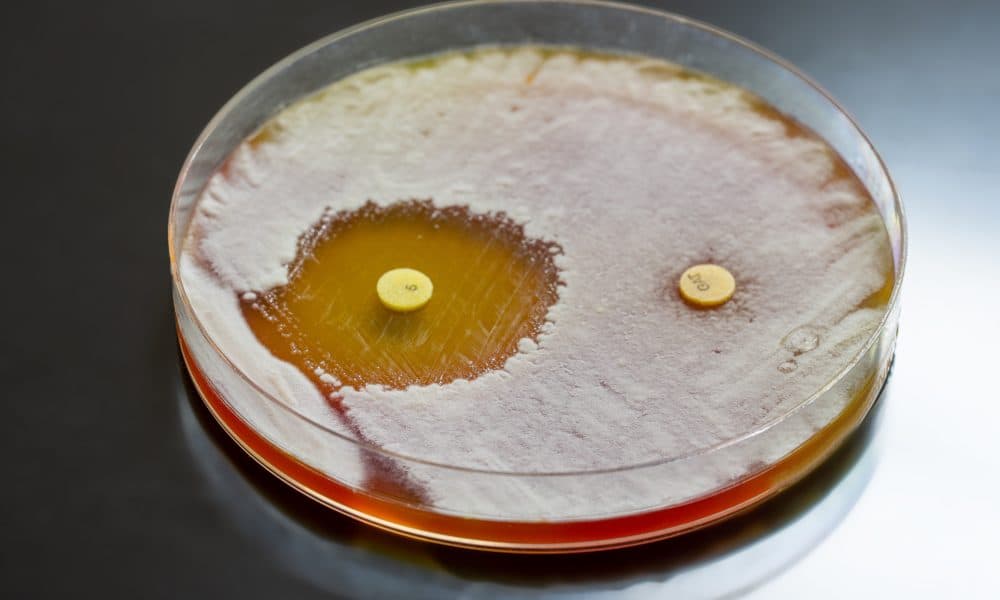
Photodisinfectant: can light curb the antimicrobial resistance crisis?

A high-tech laser disinfectant could transform how hospital-acquired diseases are kept under control.
Antimicrobial resistance contributed to 4.95 million deaths in 2019, according to the World Health Organisation. By 2050, this figure is estimated to hit 10 million annually. The economic burden meanwhile is expected to be significant, according to the World Bank which predicts that the crisis will result in US$1 trillion in additional healthcare costs by 2050.
Canadian life sciences company, Ondine Biomedical has developed a technology that seeks to combat AMR by targeting the nose with a specific type of light.
The nose is a major harbour of some of the deadliest pathogens. Its warm, moist conditions and consistent airflow make it the perfect breeding ground for superbugs to hide and flourish.
The company describes its flagship Steriwave technology as a ‘photodisinfectant’. It uses non-thermal laser light to eliminate bacterial, viral and fungal microbes without creating any antimicrobial resistance.
Steriwave is producing promising results in early-adopter hospitals, primarily across Canada. In one hospital alone, the company claims to have saved several 747 plane-fulls of patients from infections, some of whom may have otherwise died.
Vancouver General Hospital was among the first institutions to adopt the technology in 2011.
This month, an eight-year study conducted by the hospital was published in the Canadian Journal of Surgery. The research involved 13,493 patients with 8823 patients receiving Steriwave.
The paper concludes that nasal photodisinfection should be the standard of care for all patients undergoing emergent or elective spine surgeries.
It showed a 66.5 per cent reduction in surgical site infections (SSIs) following spine surgery when Ondine’s Steriwave nasal photodisinfection was implemented in the universal pre-surgical infection prevention protocol. The study also found that the hospital saved $19.9 million net over the study period (2011 to 2019).
Health Tech World hears from the company’s founder and CEO Carolyn Cross about the urgent need to address the AMR crisis and the role that photodisinfectant could play in curbing a global crisis.
Health Tech World: The AMR crisis is one of the most urgent public health crises of our time. Can you talk about the scale of the challenge ahead?
Carolyn Cross: Like climate change, there are a lot of disbelievers or there are a lot of people that say, This is not my issue, this is an issue for the future. I think that has to be dispelled right away.
I think people would be surprised that on that trajectory, where they were expecting 10 million deaths by 2050, we are actually ahead of that curve.
The death rate is climbing and the antimicrobial resistance problem is growing at a double-digit rate.
If we actually get to a point of tipping, we really change how we do life. We don’t extend life with cardiac surgeries or complex spine, we don’t even have bunion surgeries because the risk of infection becomes enormous, and yoga mats become problematic because they can give staph that is so resistant that one can’t recover easily. It’s an enormous problem.
Periodically, we get governments throwing money into a pot, but the pot is focused, unfortunately, on antibiotics. The development of antibiotics takes, according to the literature, about 10 to 20 years and about $2 billion.
There isn’t the appetite for such a long-dated project, especially when at the end of that period, resistance can come about very quickly to the very technology that you’re trying to recoup your investment in
Governments are trying very hard to come up with different models to enable and encourage this and I think this is the opportunity for breakthrough, disruptive technologies like photo disinfection.
How do you see photo disinfection playing a role in addressing those challenges?
If we can stop and prevent a lot of infections from happening on an economical and rapid basis without generating resistance, then we won’t need so many antibiotics. That, I think, is where photo disinfection absolutely does have an important role to play.
it can stop and prevent the transmission of viruses and fungi. So it’s not just about certain species of bacteria, but it’s a very broad spectrum because of that lack of resistance, because it’s economical, because it’s so easy to use and because it doesn’t have the adverse events.
There is a perfect opportunity for us to deploy this technology in a whole host of applications, whether it’s for ear infections, throat infections, nasal decolonisation, open heart surgeries or treating organs so that you can transplant organs without transplanting all the pathogens that go with it.
Something like complex spine surgeries has up to 17 to 18 per cent infection rates. 20 per cent of those infections could end up with death. You’ve got huge mortality risks complex infections that require replacements and a lot of additional resources and capacity.
There are a lot of applications and we’re looking forward to developing and making a real dent in antimicrobial resistance.
On a broader level, how do you see photodisinfectant fitting into the fight against AMR? Aside from new technologies like this, what is needed?
There has to be more recognition, support and early adoption. We need to co-create collaboratively in the healthcare systems, military systems and even consumer systems to develop safe and cost-effective approaches to novel solutions that are going to make a difference.
Thinking about the old approach and trying to replicate it will not work. We have to reimagine solutions and get behind those solutions, especially those that have demonstrated safety, efficacy and a return on investment.
I would start with that, then I think we need to socialise and politicise this a lot more because this is affecting security on a global basis. The pandemic is just one of those things that reminds us how vulnerable we are to microbes.
How does the tech work?
The technology is a combination of a light and a photosensitiser. So, the photosensitiser is first placed into the targeted area where we want targeted antimicrobial effects.
This photosensitiser is electric and positively charged and it attracts the electrically charged pathogens.
It’s basically working on an electromagnetic approach and it is using a free radical kill – a singlet oxygen approach – activated by the light to tear apart the envelope of the cells, whether it’s a virus or the bacterial cell walls. It does it generally through the lipids. Human cells are water-based and bacterial cells, for instance, are more fat-based.
Has the tech faced any scepticism or resistance from the medical community?
Of course and it’s not just our technology. In the medical industry and community, one has to have a healthy scepticism to anything new. The requirement is always: ‘Show me’. Show me why it’s better, show me that it works, show me that it’s safe, show me that it’s better than what I’m currently doing. And then show me that it saves us money and that you can supply and support us.
The first decades were about showing that this technology actually does what it says it’s going to do and that the mechanisms of action actually work. Over time, as we have worked with increasingly more hospitals that have deployed and have come to reveal excellent data and outcomes, we have been able to focus more on how we integrate.
The first decade-plus is all about demonstrating safety and efficacy over and over again in real-world experiences, and that’s what we’ve done. We have more than 100,000 patients treated, with minimal adverse events or side effects – certainly better than antibiotics.
With that track record, we’ve developed strong key opinion leaders who go up to their peers and say, ‘This really works’ and not only does it work, but it’s worked over the last 10 years.
It appears that the technology has been a success in Vancouver General Hospital where it was first rolled out. Can you tell us more about that partnership?
I’m going to give credit to Dr Liz Bryce, Titus Wong and Diane Roscoe. Those were the individuals who not only embraced the technology that we had, but they said ‘Let’s go for a whole hospital major surgery deployment right off the bat’. They made the leap.
They needed to get rid of the bugs and [they] needed to do it in a way that doesn’t generate resistance. We started there and we ended up with gangbuster results and continued to expand to more and more surgeries. As they did that they went to extraordinarily low levels of infection rates, which is what helped propel us.
You have recently started working with Mid-Yorkshire NHS Trust. Tell us about this partnership and your work bringing this tech to the UK.
We’re delighted to be working with this group. They are very innovation-forward and on top of that, they are very passionate about the role they can play in antimicrobial or antibiotic resistance stewardship.
There is a good conversation to be had and we see the hospital deploying that education to the broader community of the roles that new technology – and their willingness to adopt new technologies – can play.
When you have like-minded, kindred spirits in terms of what it is that we’re trying to do, and one’s responsibility to set the stage for the future, that is an extraordinary sweet spot. In that facility, we have now implemented a pilot study.
But we’ve been in the UK before. Prior to that, we have been in London Bridge Hospital with Professor Claire Hopkins. She’s been using this for over five years.
She’s an otorhinolaryngologist (ENT). She has found that when you use when we decolonise the nose before her sinus surgeries, there is an 80 per cent reduction in the amount of antibiotics her patients need to consume after that surgery.
What is Ondine’s status in the US currently?
We have been working diligently for many years with our collaborative partner Hospital Corporate America (HCA). We are doing our clinical studies at those facilities and we are in the final stages of crossing the T’s and dotting the I’s with the FDA on protocol prior to launching our final phase III clinical trial that is hoping to start in the first quarter of next year.
What is the cost-saving potential of photodisinfectant?
The literature shows us that in Europe 6 per cent of public sector hospital budgets are related to hospital-acquired infection. When you apply that cost of an infection and divide it by all the patients, you get a tax of about $300 per patient. In the US, it’s closer to $800 shockingly.
If you have an intervention that cuts that down by half then you have an enormous and instant win on your hands. We have done the health economics which is soon to be published where we save about £50 per patient net of the treatment.
What is in the pipeline for Ondine?
We have seven products in the pipeline. In time, we will be developing different shapes of products and different types of formulas and then different light-activating devices for the military, consumers, hospitals, long-term care facilities, animals, the list will go on.
This technology is the only one we know of that can instantly kill the deadliest bugs out there in minutes. That certainty and that confidence is driving us to work hard to bring that product pipeline to market as quickly as possible.










